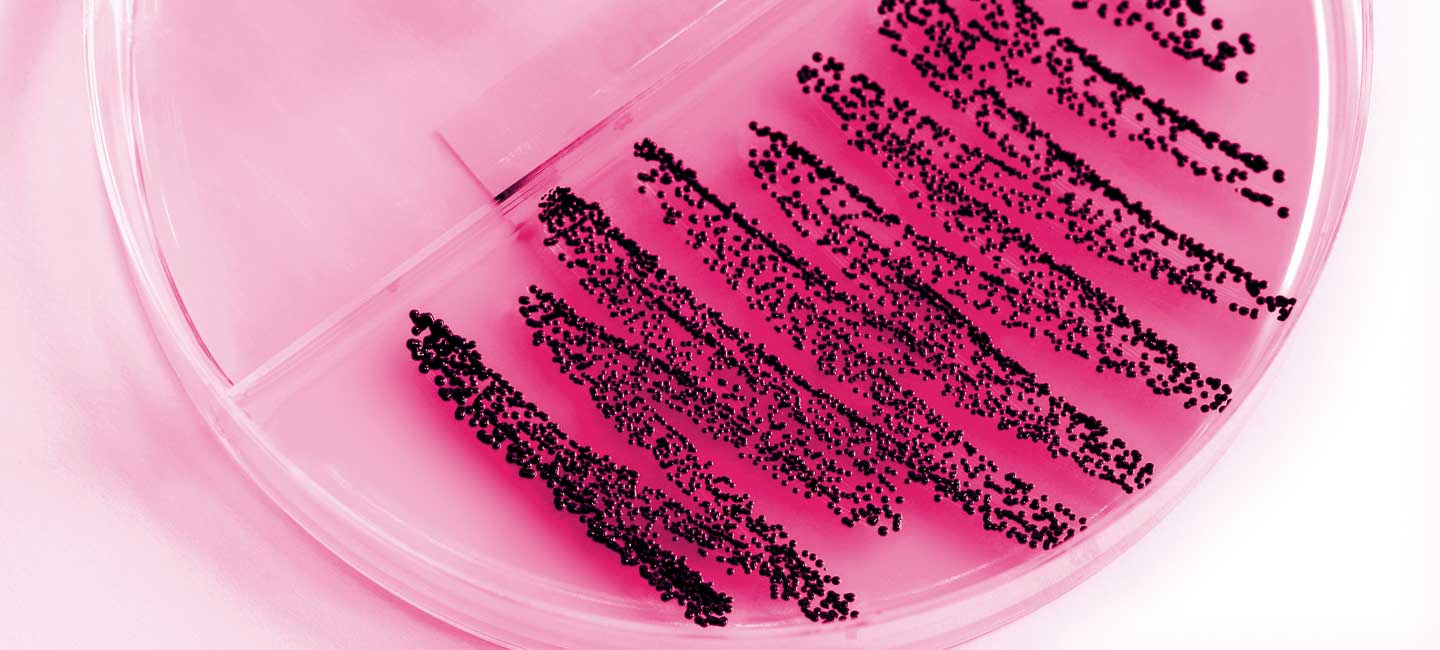

You Have an Abnormal Pap Smear—Now What?
This year, about 13,000 new cases of cervical cancer will be diagnosed in the United States. Nearly all cases of cervical cancer can be traced back to the human papillomavirus (HPV), so the best ways to protect against cervical cancer are the HPV vaccine and regular screening—a Pap Smear, HPV test or a combination of the two.
Receiving an abnormal test result can be scary and confusing. Here’s five questions you should ask your doctor to make sure you take the proper next step.
1. What does “abnormal” mean?
Abnormal results typically mean one of three things: there’s inflammation that’s probably nothing to worry about, you have HPV, or your doctor has identified potentially precancerous cells. It’s important to remember if you don’t receive a normal result, it doesn’t mean that you have cancer. Ask your doctor for more information on what they found during your Pap smear and how that will determine their next steps.
2. Will I need more tests?
Depending on your situation, your doctor may recommend different follow-up testing options. You may be asked to come in for a repeat Pap test, an HPV test, or a colposcopy, which is when the doctor examines your cervix with a microscope and may take a small biopsy.
3. Do I need a biopsy?
If your doctor notices any suspicious changes during a colposcopy, they’ll take a small piece of tissue to biopsy. Most people say it’s uncomfortable, but not very painful. If the biopsy results come back negative and show no precancerous cells, you will probably be asked to come back in for a repeat Pap smear with or without a HPV test.
4. What if my biopsy comes back positive?
If your biopsy comes back positive, your doctor may recommend an excisional treatment. There are different types of treatments so make sure you ask your doctor about the risks and benefits and which is best for you.
5. Should I be tested more often moving forward?
After an abnormal Pap smear, you may need to be screened more frequently for some time. Your doctor will outline the best screening schedule for you.